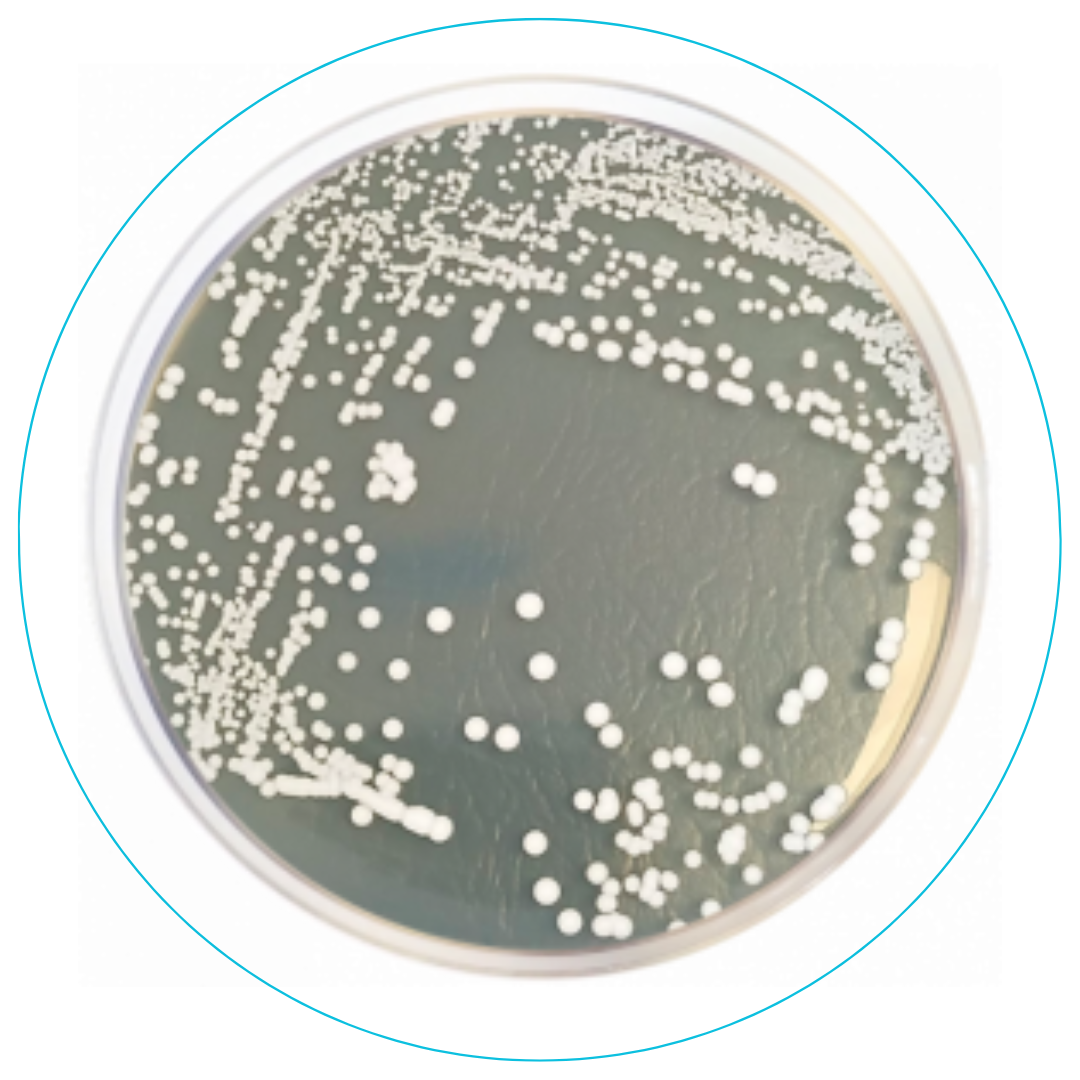
8

Nos especializamos en ofrecer soluciones biotecnológicas
que impacten positivamente en la industria de las bebidas alcohólicas así como en el ámbito animal, celular, humano y vegetal.
En ininbio nos respalda
Un sólido sustento científico.
Compromiso con la excelencia y la innovación.
Superar las expectativas de nuestros clientes.
Contribuir al éxito de sus iniciativas.
Generar con nuestros clientes una sustentabilidad global.






Descubre nuestros nutrientes clave para la fermentación alcohólica, diseñados para asegurar una fermentación eficiente y de alta calidad
Ofrecemos productos especializados para la industria del tequila, cerveza, whisky, ron, vodka, mezcal, charanda y bacanora, garantizando calidad y excelencia en cada proceso de producción.
Laboratorio I+D+I

Aislamiento de microorganismos
Realizamos el aislamiento de microorganismos (principalmente levaduras) con el propósito de obtener cultivos axénicos (puros) a partir de muestras ambientales, industriales o biológicas.
Identificación de levaduras
Aseguramos la identificación puntual de hasta de hasta 12 tipos de levaduras axénicas o en consorcios, por técnicas de amplificación de ADN (RT-qPCR) en el sistema MIC.
Propagación de levaduras
Promovemos la propagación de levaduras y diseño de fermentaciones en el sistema automatizado Livit Flex (único en Latinoamérica).
Diseño de fermentaciones
Además del sistema Livit flex, contamos con el sistema ez2-Control, un segundo equipo para la propagación y diseño de fermentaciones.
Diseño de fermentación personalizado
La optimización de la fermentación alcohólica es realizada en el sistema AFM, mediante diseños factoriales independientes, con sistemas de detección automatizados, evaluados cada minuto.
Cuantificación de compuestos
Contamos con un equipo de cromatografía de gases acoplado a un detector de ionización de flama (GC-FID, Agilent) y proximamente acoplado a espectroscopía de masas.
NUTRICIÓN ANIMAL
En Ininbio Animal Care redefinimos la nutrición animal con soluciones avanzadas diseñadas para potenciar la salud y el rendimiento de tus animales.
Vacuno
Porcino
Avicultura
Acua
Equinos
Mascotas
Impulsa
Su longevidad y productividad.
Mayor calidad
En productos como leche, carne y huevos
Impacto positivo
En la rentabilidad y la sostenibilidad.







ININBIO SYSTEM
Innovación continua
Ininbio SYSTEM, es el primer sistema de monitoreo integrado a nivel mundial para el seguimiento preciso de la fermentación de las bebidas alcohólicas.
- Temperatura
- pH
- Riqueza alcohólica
- Volumen de la tina
- Grados brix
- Conectividad en tiempo real